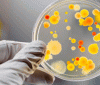
На території Вінниці зареєстровано 3 випадки сальмонельозу

У Вінниці розпочалась активна фаза очистки Південного Бугу. Роботи проводять в районі «Вінницяоблводоканалу». Тут працюють три земснаряди, екскаватор-амфібія та баржа. Згодом приступлять до робіт поблизу острова Кемпа. У цьому році масштабний проєкт з очистки річки стартував навесні і тривав до початку нересту, після чого зробили перерву до літа.
"Очищення русла Південного Бугу в межах Вінниці – це один з ключових проєктів для вінницької громади, адже ріка є джерелом питної води для майже 400-тисячного міста. І вінницький муніципалітет – єдиний, хто в Україні взявся за такий масштабний, складний та дороговартісний проєкт. Він фінансується коштом міського бюджету і розрахований на декілька років. А стартував – у 2020-му",- йдеться у повідомлені
Загалом, у рамках проєкту, заплановано очистити Південний Буг від об’їзного мосту до Сабарівської ГЕС. У 2020 році відпрацювали ділянку протяжністю понад 1 км, - від об’їзного мосту у напрямку міста, - і викачали близько ста тисяч кубометрів намулу. В результаті річка в деяких місцях поглибшала до 4-6 м, а течія стала більш інтенсивною.
Наразі Вінниця – єдина громада, яка реалізує власними зусиллями такий масштабний проект оздоровлення головної водної артерії міста. Загалом, щоб очистити більше 13 км русла у межах Вінниці, знадобиться не менше 6-7 років. Також важливо проводити й інші комплексні рішення з модернізації інфраструктури водопостачання. Якісна і безпечна вода для вінничан є важливою ціллю у головному документі громади – Стратегії «Вінниця 3.0.».